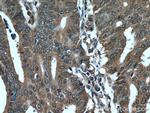
PDCD5 Antibody in Immunohistochemistry (Paraffin) (IHC (P))

Search
Proteintech
PDCD5 Polyclonal Antibody
{{$productOrderCtrl.translations['antibody.pdp.commerceCard.promotion.promotions']}}
{{$productOrderCtrl.translations['antibody.pdp.commerceCard.promotion.viewpromo']}}
{{$productOrderCtrl.translations['antibody.pdp.commerceCard.promotion.promocode']}}: {{promo.promoCode}} {{promo.promoTitle}} {{promo.promoDescription}}. {{$productOrderCtrl.translations['antibody.pdp.commerceCard.promotion.learnmore']}}
产品信息
12456-1-AP
种属反应
已发表种属
宿主/亚型
分类
类型
抗原
偶联物
形式
浓度
规格
纯化类型
保存液
内含物
保存条件
运输条件
产品详细信息
Immunogen sequence: MADEELEAL RRQRLAELQA KHGDPGDAAQ QEAKHREAEM RNSILAQVLD QSARARLSNL ALVKPEKTKA VENYLIQMAR YGQLSEKVSE QGLIEILKKV SQQTEKTTTV KFNRRKVMDS DEDDDY (1-125 aa encoded by B C015519)
靶标信息
Programmed cell death 5 (PDCD5), a human apoptosis-related protein, is thought to play an early and universal role in apoptosis. PDCD5 is widely expressed and is upregulated in cells undergoing apoptosis, where it translocates rapidly from the cytoplasm to the nucleus. PDCD5 has a compact core structure of low flexibility with two mobile alpha-helices at N-terminal and a flexible unstructured C-terminal region. The charged residues are crucial for the ability of apoptosis-promoting and cell translocation of the protein. PDCD5 can facilitate apoptosis and enhance TAJ/TROY-induced paraptosis-like cell death. PDCD5 may play a dual role in the Tip60 pathway. It interacts with Tip60 and functions as a Tip60 co-activator to promote apoptosis. The nucleotide polymorphisms in the 5'-upstream region of PDCD5 affect promoter activity and the susceptibility of a Chinese population to develop chronic myelogenous leukemia and may represent a novel tumor suppressor gene influencing lung cancer.
仅用于科研。不用于诊断过程。未经明确授权不得转售。
生物信息学
蛋白别名: apoptosis-related protein; PDCD5; Programmed cell death protein 5; Protein TFAR19; TF-1 cell apoptosis-related protein 19; TF1 cell apoptosis-related gene 19; TFAR19 novel apoptosis-related; unnamed protein product
基因别名: PDCD5; TFAR19
UniProt ID: (Human) O14737
Entrez Gene ID: (Human) 9141